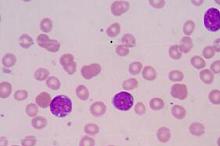
免疫抑制治疗低风险MDS 可成功减轻输血负担及相关后遗症

-
具有和不具有性腺功能减退的男性 睾酮治疗需谨慎
环球医学资讯
2020年03月25日
点击量:583
1小时条评论近期,美国学者发表在《JAMA Intern Med》的一项研究,考察了具有和不具有性腺功能减退的男性睾酮治疗与静脉血栓栓塞(VTE)风险的相关性。 重要性:睾酮治疗越来越多地处方于未确诊性腺功能减退的患者中。该疗法可能通过多种机制与VTE风险的增加相关,包括红细胞压...
-
机械通气ICU患者:无镇静vs轻度镇静 90日死亡率无差
环球医学资讯
2020年03月19日
点击量:319
1小时条评论对危重机械通气患者来说,不镇静或轻度镇静对死亡率影响有差异吗?2020年2月,发表在《N Engl J Med.》的一项多中心、随机、对照试验,回答了这一问题。 背景:在危重、机械通气患者中,每日镇静中断治疗可以减少通气时间和重症监护病房(ICU)住院时间。同轻度镇静...
-
丙磺舒如何影响氟氯西林药效?
环球医学资讯
2020年03月13日
点击量:297
1小时条评论2020年1月,新西兰和澳大利亚学者发表在《J Infect》的一项研究,考察了丙磺舒和食品对健康志愿者氟氯西林药代动力学和药效学的影响。 目的:旨在测量在禁食和进食的情况下,丙磺舒对氟氯西林药代动力学和药效学终点的影响。 方法:11名健康志愿者空腹时,仅给予口...
-
免疫抑制治疗低风险MDS 可成功减轻输血负担及相关后…
环球医学资讯
2020年03月11日
点击量:298
1小时条评论免疫抑制治疗(IST)是治疗低危骨髓增生异常综合征(MDS)的一种治疗方法。然而,使用几种不同的免疫抑制方案,缺乏高质量的研究,以及缺乏有效的预测性生物标记物是重要的挑战。2020年1月,发表在《Haematologica.》的一项系统评价和荟萃分析显示,IST治疗低风险的M...
-
同种异体造血干细胞移植患者:如何预判终止免疫抑制…
环球医学资讯
2020年03月11日
点击量:266
1小时条评论如何预判同种异体造血干细胞移植(HCT)患者成功终止免疫抑制治疗的可能性?近期发表在《JAMA Oncol》的一项研究,为这一难题提供了答案。 重要性:同种异体造血干细胞移植后常规尝试终止免疫抑制治疗,按照目前的做法,可能导致移植物抗宿主病(GVHD)相关发病和死...
-
重症患者快速纠正维生素D缺乏 或是无效举措
环球医学资讯
2020年03月06日
点击量:237
1小时条评论维生素D,为大家熟知的是其骨骼健康的作用。随着医学的发展,才发现我们明显小看了维生素D,他的作用不仅是这些。在重症患者中,维生素D缺乏可能是一种常见潜在可逆转的死亡率和发病率的促进因素。2019年12月,发表在《N Engl J Med》的一项3期试验,调查了维生素D缺...
-
健康成人摄入150~900 mg柚皮素安全
环球医学资讯
2020年03月05日
点击量:728
1小时条评论柚皮素是一种在橙子和其他柑橘类水果中发现的黄酮类化合物。2020年1月,发表在《Diabetes Obes Metab》的一项随机、对照、单一升高剂量的临床试验显示,健康成人摄入150~900mg的柚皮素是安全的,并且血清浓度与剂量成正比。 目的:评估食用整个橙子(Citrus sinens...
-
随机临床试验中盲法对估计治疗效果的影响:Meta流行…
环球医学资讯
2020年02月28日
点击量:339
1小时条评论随机临床试验中盲法对估计治疗效果的影响如何呢?2020年1月,发表在《BMJ》的一项Meta流行病学研究给出了答案。 目的:旨在研究盲法对试验间估计治疗效果以及差异的影响;区分患者、医疗保健提供者和观察者设盲;检测偏倚和性能偏倚;结局类型。 设计:Meta流行病...
-
维生素D缺乏症患者:口服维生素D3补充剂增加血清FGF…
环球医学资讯
2020年02月20日
点击量:264
1小时条评论当前,维生素D补充剂可增加维生素D缺乏患者的血清成纤维细胞生长因子23(FGF23)浓度的研究结果不一致。2019年11月,发表在《Osteoporos Int》的一项系统评价和荟萃分析证实,口服维生素D3补充剂能增加维生素D缺乏患者血清FGF23的浓度。 研究证实,维生素D补充剂可...
-
奥司他韦对不同类型重症流感并不等效
环球医学资讯
2020年01月21日
点击量:259
1小时条评论2018年2月,微信长文《流感下的北京中年》受到广泛的关注,更是让大众更加真切的认识了流感。2019年11月,发表在《Clin Infect Dis.》的一项研究,调查了早期使用奥司他韦对不同类型重症流感患者死亡率的影响。 背景:神经氨酸酶抑制剂能否降低流感患者死亡率,现有...

会员登录

